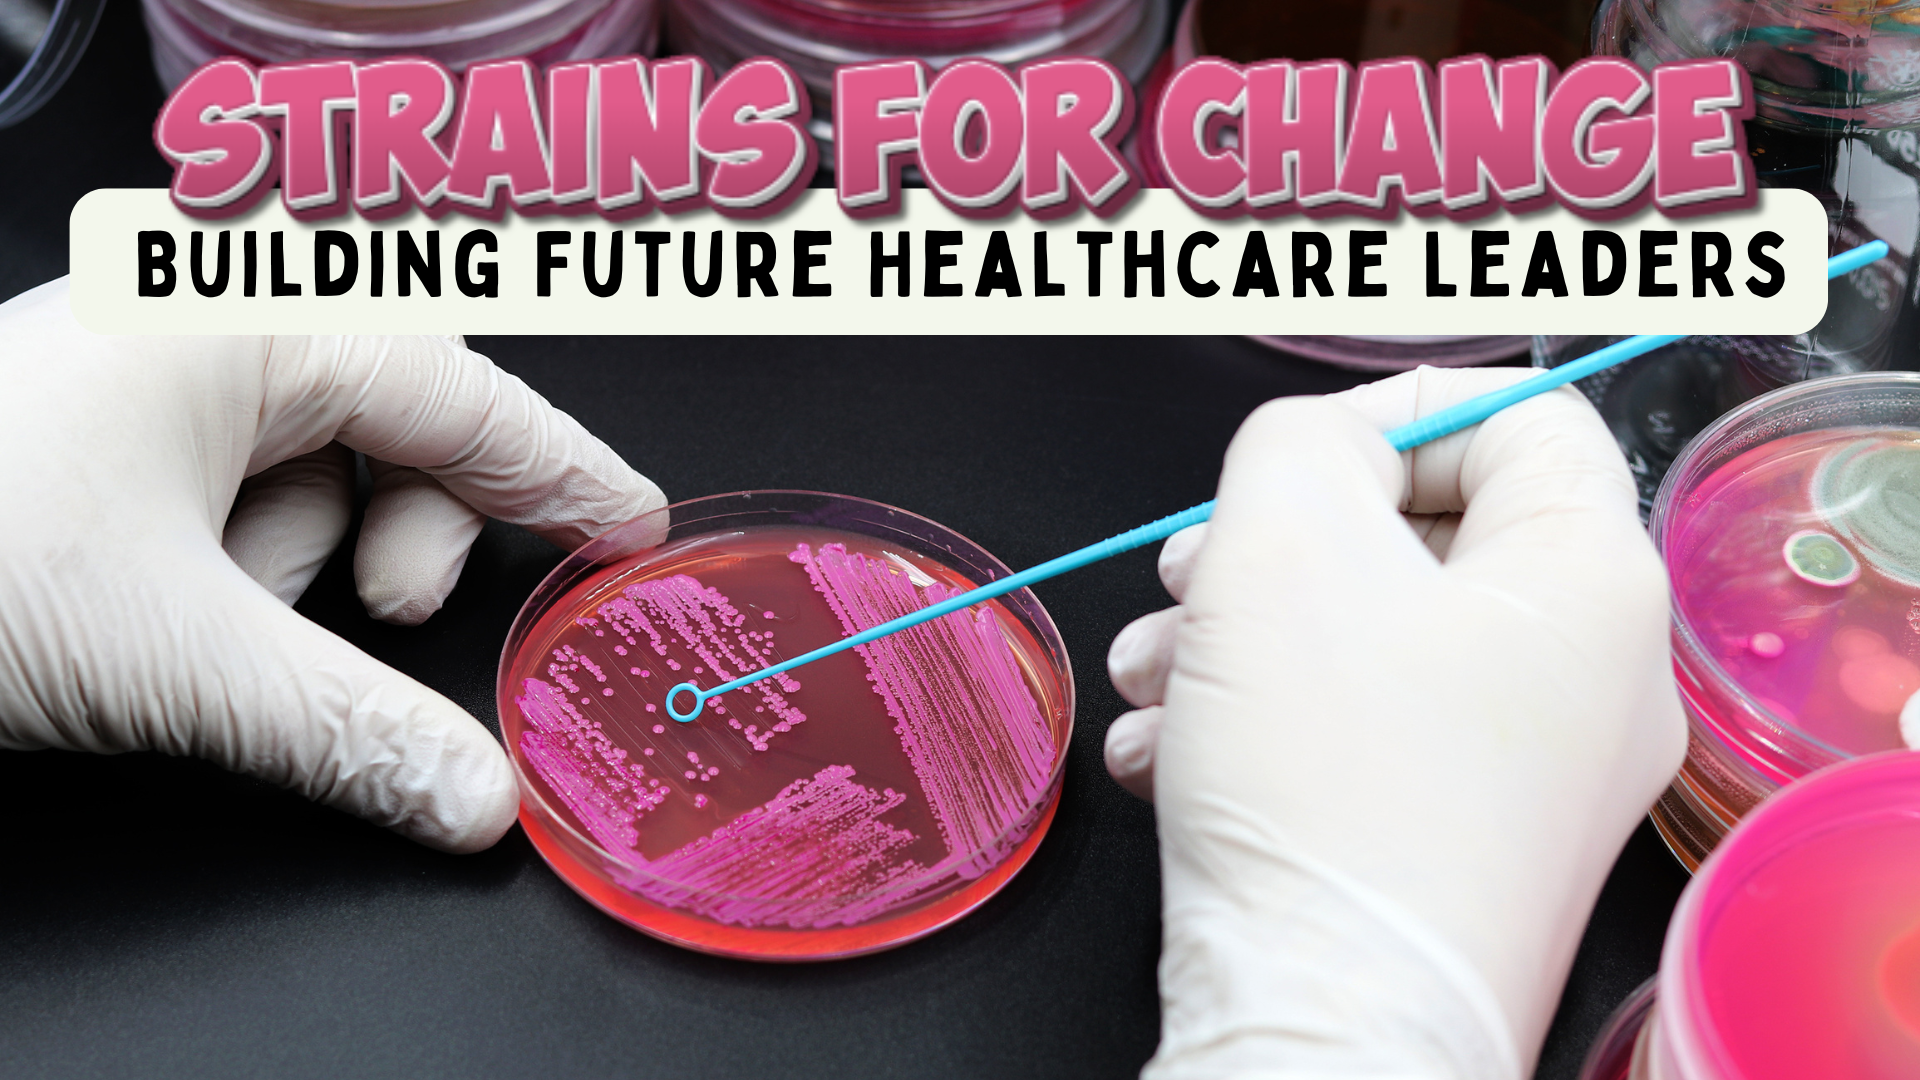

Grade: 11-12
Teacher Name: Jodie Deinhammer
Description and purpose of grant:
This grant is requesting funding to purchase essential medical microbiology lab supplies that will allow our students to move beyond textbooks and truly experience science in action. With these resources, students will be able to culture and analyze microorganisms, practice aseptic technique, and explore the real-world applications of microbiology in medicine and public health.
The objective of this grant is to provide students with hands-on learning opportunities that strengthen their scientific skills, critical thinking, and problem-solving abilities—tools they will carry into future health care, research, and community service careers. By engaging students directly with the science of microbes, we aim to prepare them not just as learners, but as the next generation of health care leaders and innovators.
This initiative directly supports our campus and district goals of college and career readiness, STEM education, and authentic, project-based learning experiences. By investing in lab supplies today, we are investing in our students’ futures—and in the health and well-being of the communities they will one day serve.
Implementation process:
The funds from this grant will be used to purchase medical microbiology lab supplies that will be immediately incorporated into real-world investigations during the current school year. Approximately 100 students enrolled in Medical Microbiology will directly benefit from these hands-on experiences, which include culturing microorganisms, testing antimicrobial effectiveness, and practicing laboratory safety techniques. These supplies are durable and reusable, ensuring that the grant will have an impact well beyond a single year. Future classes of students will also use this equipment, allowing us to sustain meaningful, experiential learning opportunities for hundreds of students over the coming years. By embedding these materials into our curriculum, we ensure that students consistently have access to authentic, inquiry-based science education that builds both their content knowledge and their readiness for health science careers.
Items you plan to purchase with grant money
Bunsen Burners and cords, Petri Dishes, Bacteria Transformation Kit, Common Mold and Rhizopus Slides, Bacterial Synergy Lab, Differential Media Kits, and Oils Collection for Experimentation and Design Lab
In the event my grant is not fully funded, this is the minimum amount I would need to get started on this project:
$1000
Trishun Fitzgerald
